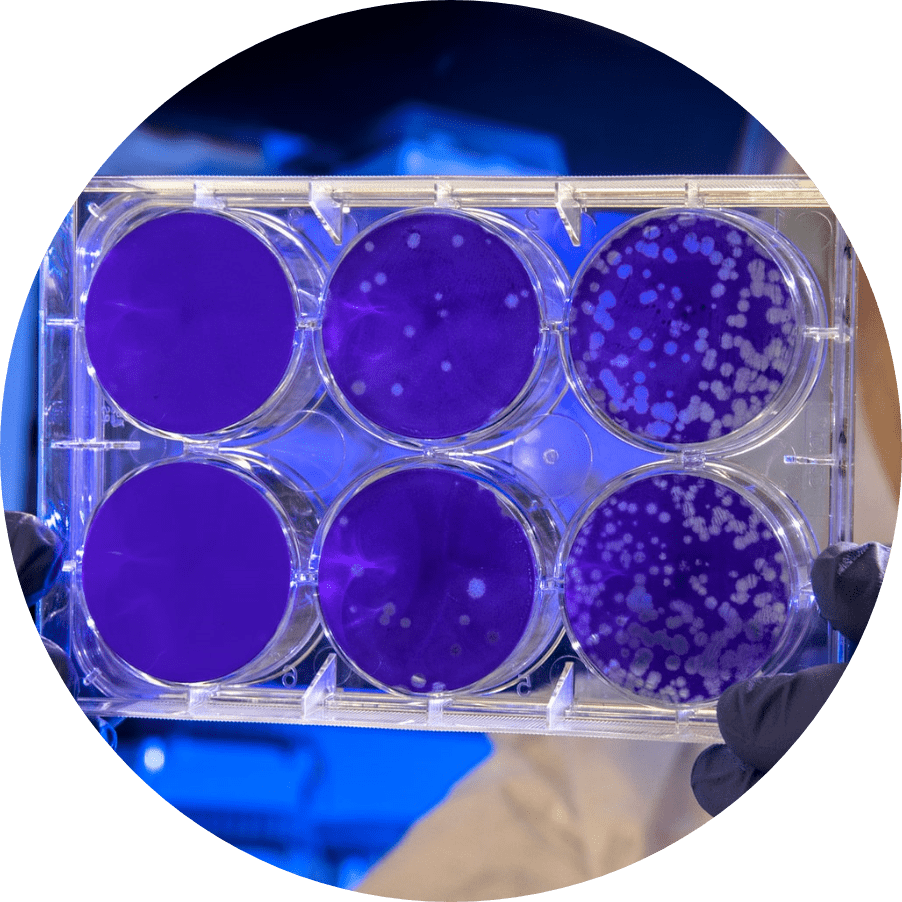

伝統と未来が調和する
ホテル椿山荘東京は、世界都市 東京のなかで、いつの時代も緑のオアシスとして癒しをご提供し続けてまいりました。先端医療技術を応用した再生医療専門クリニックとこの地で新たな歴史を刻んでまいります。
ホテル椿山荘東京
×
N2 クリニック
ホテル椿山荘東京
四季折々の美しい景観に抱かれたラグジュアリーホテル
都会のオアシスと讃えられる広大な庭園に囲まれたホテル椿山荘東京は日本ならではの風情とおもてなし、世界基準の一流のサービスでくつろぎのひとときを提供いたします。
N2クリニック
黎明期からの格式ある再生医療専門クリニック
第二種および第三種再生医療提供計画を届出しているN2クリニックは、安全性と治療実績で国内外のゲストから、厚い信頼を得ています。


再生医療
脂肪組織由来幹細胞による幹細胞療法(第二種再生医療)を提供いたします。
また、細胞を用いた再生医療以外に幹細胞が分泌する機能性成分を応用した培養上清療法も実施しています。
第一線で活躍する再生医療の経験豊富な医師が安全性の高い再生医療を提案いたします。

-
- 幹細胞療法
- ご自身の脂肪組織由来幹細胞を細胞培養により増殖し、静脈注射や局所注射により投与することで、損傷した組織を修復・再生することが期待できます。
-
- 免疫細胞療法
- 細胞培養処理により、増殖・活性化させたNK細胞・T細胞・樹状細胞などの各種免疫細胞を投与することで、免疫力を増強することが期待できます。
-
- 細胞加工施設
- 再生医療の安全性と品質を支えているのは細胞培養技術です。
当院は、N2クリニック 四谷 院長の照沼 裕が代表を務める日本バイオセラピー研究所と連携しています。
幹細胞療法
脂肪組織の中に存在する幹細胞をもちいた再生医療です。
ご自分の細胞であるため拒絶反応はなく安全性の高い治療です。
0day
- 血液検査・治療説明
- 脂肪採取を行う前に血液検査と医師による治療の
ご説明をいたします。

腹部よりごく少量の脂肪組織を脂肪吸引により採取します。施術は経験豊富な日本形成外科学会認定 形成外科専門医により、体へのダメージが少なくなるように管理しておこないます。

1day
採取した脂肪組織はただちに最適な保存状態にたもち細胞加工施設に輸送します。そのなかにごく少量含まれる幹細胞を極めて高い精度で分離し細胞培養処理により数千万倍に増殖させます。 幹細胞の持つ組織修復の機能を損なわないために、緻密な細胞管理環境が維持されます。
翌日よりシャワー浴は可能です。
7days
入浴・運動の制限がなくなります。

35days
幹細胞の培養処理が完了し初回投与が可能となります。投与日までは幹細胞の品質を維持したまま冷凍保存しますので、これ以降はご希望の際に幹細胞投与を行えます。
2回目以降の投与の際には、投与予定日に目標数の細胞数になるよう調節して、冷凍保存してある幹細胞を解凍・細胞培養を行えます。細胞培養により高効率に細胞数を増やすことができますので、一度の脂肪吸引で複数回の幹細胞投与が可能です。

60days
120days


症状の程度に応じて、1ヶ月~3ヶ月ほど間隔をあけての2回目以降の治療をおすすめしておりますが、ゲストの体調やご都合にあわせての治療スケジュールをご提案いたします。
治療までの手順
当院は完全予約制です。
院内でほかのゲストとお会いすることなく、プライベートな環境で治療を受けていただいております。
-
ご予約
お電話またはフォームにて、予約のご希望をお伝えください。日程調整後、当院より折り返しご連絡いたします。
-
カウンセリング
ご希望内容の確認や最適な治療のご提案のため
必要な際はカウンセリングの内容を調整させていただきます。 -
受診当日
医師の診察および説明後に各種治療をおこないます。
-
フォローアップ
治療の内容に応じて万全のアフターケアをご用意しております。
Moving image
N2 CLINICホテル椿山荘東京院
